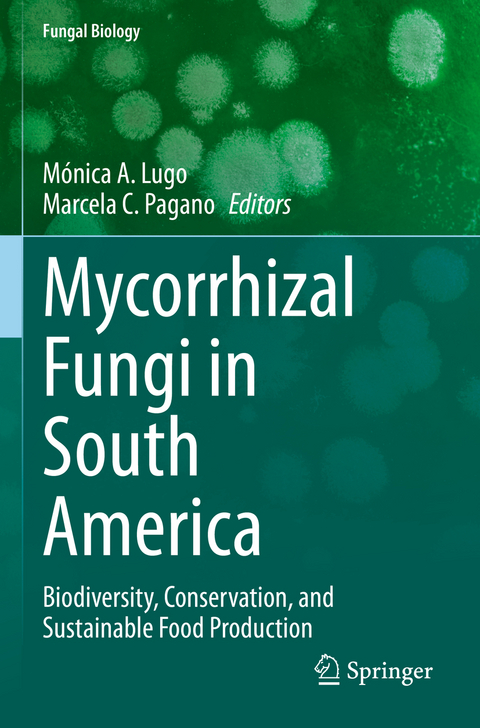
Mycorrhizal Fungi in South America -

Mycorrhizal Fungi in South America
Springer International Publishing (Verlag)
978-3-031-12996-4 (ISBN)
Soils are a major aid in food production in all terrestrial ecosystems; however, this means they are also involved in gas emission and global warming.Thus, in agronomic ecosystems, several mitigation practices have been proposed to promote the increase of carbon soil stock, and the reduction of warming gas emission from soils. In South America, most of the rural population depends economically on agriculture and usually works in family units. New, organic, safe, and sustainable agro-forestry practices must be applied to support local communities and countries to achieve hunger eradication, rural poverty reduction, and sustainable development.
This book compiles new information for mycorrhizal occurrence in natural and anthropic environments in South America. It includes new reports of mycorrhizal fungi diversity along different mycorrhizal types and their effect on plant communities, plant invasions, the use of mycorrhizal fungi for ecological and sustainable studies, management programs of natural and agroecosystems, and forestry and food-secure production. This book fills the gaps in biodiversity knowledge, management and safe food production of mycorrhizas. It should be a valuable help to researchers, professors and students, to aid in use of mycorrhizal fungi while also focusing on their biodiversity, sustainable safe food production, and conservation perspectives.
lt;b>Prof. Dr. Mónica Alejandra Lugo MICODIF- IMIBIO-CONICET-UNSL- Facultad de Química, Bioquímica y Farmacia, 5700, San Luis, Argentina. e-mail lugo@unsl.edu.ar/monicalugo63@gmail.comML was born in Tigre, Argentina. She taught for 28 years at high school and Universities such as National University of Buenos Aires, National University of Córdoba and National University of San Luis; and her current positions are Adjunct professor (Biology Department, FQByF, National University of San Luis) to Bachelor of Biological Sciences and to Professor in Biological Sciences, becoming Professor of Vegetal Diversity I, Plant-Fungi interactions: Mycophyllas and Mycorrhizas, Biology of Protist and Fungi and Fungi and Vegetal Systematic. She won three Doctoral Scholarships (1994-1999) and a Postdoc Fellowship (1999-2001). Further, she is the Director of the Mycology, Diversity and Fungal Interaction Herbarium (MICODIF) of the National University of San Luis-SNDB (National System of Biological Data-Argentina).Education: Dr. Lugo completed her D.Sc. (Biological Sciences) from National University of Córdoba, Argentina.Experience: She has worked in diverse research topics such as: Plan-Fungi associations (stem fungal endophytes/mycophyllas, arbuscular mycorrhizas and dark septate endophytes, ectomycorrhizas ecology), Environmental Microbiology (plants and soil microorganism interactions in highlands, stressed, arid and semi-arid native and agronomic ecosystems, secondary communities), Mycology, fungal diversity, etc.Publication: Since 1995, 30 papers published in national and international peer reviewed journals like Microbial Ecology, Mycologia, Symbiosis, Mycorrhiza, Pedobiologia, Journal of Arid Environments, Plant and Soil, etc., published also 6 Book Chapters, 1 Book of Research Methodologies, 3 Didactic and Research Books from different editorial such as NOVA Science Publishers, and SpringerInternational collaboration: Dr. Lugo also collaborate in research projects in Argentina, Colombia, Italy and with other research groups.Editorial Experience: She has reviewed research works as expert reviewer of International Journals (Applied Soil Ecology, Fungal Ecology, Microbial Ecology, Mycorrhiza, Symbiosis, etc.) and National Journals.Specialization Keywords: Plant-soil interactions /soil ecology, mycorrhizic fungi, plant symbiosis/arid, semiarid, highlands, stressed environments
Dr. Marcela Claudia PaganoMarcela Pagano was born in La Plata, Argentina. She taught for some years at high school and Universities. In 2018 she was appointed as Technical analyst in Health Promotion and Management at Sanitary Surveillance Board, Santa Catarina, Brazil. Prior to that, she spent over 10 years in mycorrhizal research, completing her PhD at the Federal University of Minas Gerais, Brazil and four postdoctoral fellowships.Education: Dr. Pagano completed her D.Sc. (Sciences - Applied Botany) and her MSc in Ecology, Conservation and Wild Life Management from Federal University of Minas Gerais, Brazil.Experience: She has vast experience in different areas of plant-soil-fungal biology, to name a few: Rhizobial and mycorrhizal symbiosis, Nanomaterials focusing on anthropogenic soils and biochar, terrestrial ecology, etc.Publication: Since 1998, 28 papers published in national and international peer reviewed journals like Ecological Indicators, Applied Soil Ecology, Symbiosis, Soil & Tillage Research, etc. and from different journals of Elsevier, Springer, etc.International collaboration: Dr. Pagano also collaborate in research projects in Brazil and with other research groups, which has resulted in 27 book chapters and 2 edited books.Editorial Experience: She is editorial board member of three International Journals (European Journal of Soil Biology, Frontiers in
1. Overview.- 2. Ectomycorrhizal fungi invasions in Southern South America.- 3. Pseudomonotes tropenbosii, an endemic Dipterocarp tree from a Neotropical terra firme forest in Colombian Amazonia that hosts ectomycorrhizal fungi.- 4. Arbuscular Mycorrhizal Fungi in the Colombian Amazon: A Historical Review.- 5. AMF diversity in coffee and cacao agroforestry systems: importance for crop productivity and forest conservation.- 6. Potential of arbuscular mycorrhizas for the remediation of soils impacted with pollutants.- 7. Diversity of Arbuscular Mycorrhizal Fungi in the Ecuadorian Amazon region..- 8. Orchid Mycorrhizas in South America: Tropical and Subtropical Ecosystems.- 9. Symbiotic propagation of South American orchids.- 10. Arbuscular mycorrhizal fungi in agroecosystems of East-Central Argentina: two agricultural practices effects on taxonomic groups.- 11. Metal soil contamination, metallophytes and arbuscular mycorrhizal fungi from South America.- 12. Native and exotic woodland from Patagonian Andes: Anthropic impacts and Mycorrhizas.- 13. Current Knowledge on Mycorrhizal Symbiosis and Endophytes in northwest Patagonia, Argentina.- 14. Mycorrhizas in Nothofagus from South America: what do we know from nursery and field experiences?.- 15. Arbuscular mycorrhizal fungi in the Espinal Ecoregion, gaps and opportunities.- 16. Edible ectomycorrhizal mushrooms in South America.- 17. Arbuscular mycorrhizal symbiosis in temperate grassland forage species of Argentina.- 18. Current trends and challenges in viticulture using arbuscular mycorrhizal fungi.- 19. Communities of Glomeromycota in the Argentine Arid Diagonal: an approach from their ecological role in grassland management and use.- 20. The current scenario of the distribution, functionality and ecosystemic role of the arbuscular mycorrhizal symbiosis in Chile.- 21. Mycorrhizas and Restoration in South America.- 22. Gaps in South American mycorrhizal biodiversity and ecosystem function research.
| Erscheinungsdatum | 31.10.2023 |
|---|---|
| Reihe/Serie | Fungal Biology |
| Zusatzinfo | VIII, 465 p. 65 illus., 58 illus. in color. |
| Verlagsort | Cham |
| Sprache | englisch |
| Maße | 155 x 235 mm |
| Gewicht | 724 g |
| Themenwelt | Naturwissenschaften ► Biologie ► Genetik / Molekularbiologie |
| Naturwissenschaften ► Biologie ► Mikrobiologie / Immunologie | |
| Naturwissenschaften ► Biologie ► Mykologie | |
| Schlagworte | Fungi • Microbiology • mycorrhizas • plant symbioses • Soil |
| ISBN-10 | 3-031-12996-2 / 3031129962 |
| ISBN-13 | 978-3-031-12996-4 / 9783031129964 |
| Zustand | Neuware |
| Informationen gemäß Produktsicherheitsverordnung (GPSR) | |
| Haben Sie eine Frage zum Produkt? |
aus dem Bereich


